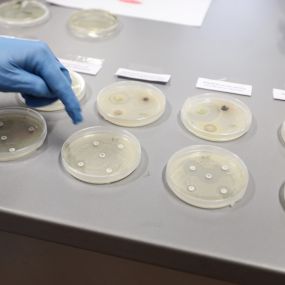

Aktualności
Sukces „Dnia Biotechnologa” na Uniwersytecie Rzeszowskim!
Z radością informujemy, że w murach Collegium Medicum Uniwersytetu Rzeszowskiego odbył się „Dzień Biotechnologa”. Wydarzenie przyciągnęło tłumy młodych pasjonatów nauki – gościliśmy aż 260 uczniów z rzeszowskich liceów, którzy chcieli z bliska przyjrzeć się fascynującemu światu biotechnologii.
Program pełen naukowych wrażeń
Dzień rozpoczął się od części oficjalnej w sali 166 B2, gdzie Władze Dziekańskie przywitały przyszłych kandydatów na studia. Uczniowie mieli okazję poznać ofertę dydaktyczną Wydziału Biotechnologii oraz dowiedzieć się, jakie perspektywy rozwoju naukowego i zawodowego czekają na absolwentów tego kierunku.
W programie wydarzenia znalazły się m.in.:
🔹 Prezentacje i wykłady: Przybliżenie życia studenckiego oraz ścieżek kariery w nauce.
🔹 Zwiedzanie laboratoriów: Uczniowie odwiedzili pracownie dydaktyczne i badawcze, gdzie pod okiem pracowników i studentów brali udział w widowiskowych pokazach naukowych.
🔹 Stoiska pokazowe: W holu budynku A0 swoje osiągnięcia prezentowały zespoły badawcze oraz studenckie koła naukowe. To tam odbywały się najbardziej bezpośrednie dyskusje o codziennej pracy biotechnologa.
Część wydarzenia była koordynowana bezpośrednio przez studentów, co pozwoliło licealistom poczuć prawdziwą atmosferę panującą na naszej uczelni. Duża frekwencja oraz ogromne zainteresowanie pokazami udowadniają, że Rzeszów to miasto młodych ludzi z ogromnym potencjałem naukowym.
Dziękujemy wszystkim uczestnikom za obecność i wspólną energię. Mamy nadzieję, że z wieloma z Was spotkamy się na zajęciach już jako studenci Biotechnologii!